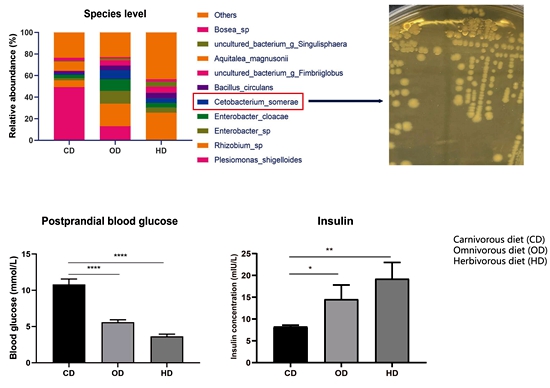

Scientists from IFRCAAS Discover the Commensal Bacterium in Fish Intestine that Regulates Fish Glucose Metabolism
Researchers from the Institute of Feed Research of the Chinese Academy of Agricultural Sciences (IFRCAAS) discovered a highly abundant bacterium in fish gut microbiota, Cetobacterium somerae, which can activate the parasympathetic nervous system through the metabolite acetate to promote insulin expression and glucose utilization in fish, and play an important role in regulating fish health. The results have been published on Gut Microbes.
Isolation of Cetobacterium somerae and its correlation with glucose metabolism
As the team's chief scientist Professor Zhou Zhigang said, the ability of fish to utilize carbohydrates is generally low. Improving the carbohydrates utilization ability of farmed fish is of practical and economic value. It is an international frontier and hot topic in fish research. Animal intestinal microbiota plays an important role in regulating the host's carbohydrates metabolism, but the mechanism is still unclear.
This study revealed that the different carbohydrates utilization of zebrafish fed different diets was mediated by the intestinal microbiota, and it has a significant positive correlation with the abundance of C. somerae in the intestine. Studies have confirmed that C. somerae can promote insulin expression in zebrafish, thereby reducing blood glucose. Acetate, the main metabolite of C. somerae, is an important factor that promotes the expression of insulin in zebrafish and reduces blood glucose level. Further studies have found that both C. somerae and acetate can activate insulin expression through activation of the parasympathetic nervous system and promote the utilization of carbohydrates in fish. The C. somerae and its regulation of glucose metabolism found in this study provide novel insights for improving the carbohydrates utilization capacity of fish, which can promote the development of functional feed supplements based on C. somerae and related prebiotics.
This research was funded by the National Natural Science Foundation of China's Outstanding Youth Fund Project and the National Key Research and Development Program.
By Ran Chao (ranchao@caas.cn)
-
 Apr 18, 2024Opening Ceremony of the Training Workshop on Wheat Head Scab Resistance Breeding and Pest Control in Africa Held in CAAS
Apr 18, 2024Opening Ceremony of the Training Workshop on Wheat Head Scab Resistance Breeding and Pest Control in Africa Held in CAAS -
 Apr 03, 2024IPPCAAS Co-organized the Training Workshop on Management and Application of Biopesticides in Nepal
Apr 03, 2024IPPCAAS Co-organized the Training Workshop on Management and Application of Biopesticides in Nepal -
 Mar 28, 2024Delegation from the School of Agriculture and Food Science of University College Dublin, Ireland Visit to IAS, CAAS
Mar 28, 2024Delegation from the School of Agriculture and Food Science of University College Dublin, Ireland Visit to IAS, CAAS -
 Mar 25, 2024Director of World Food Prize Foundation visited GSCAAS
Mar 25, 2024Director of World Food Prize Foundation visited GSCAAS -
 Mar 20, 2024Institute of Crop Sciences (ICS) and Syngenta Group Global Seeds Advance Collaborative Research in the Seed Industry
Mar 20, 2024Institute of Crop Sciences (ICS) and Syngenta Group Global Seeds Advance Collaborative Research in the Seed Industry
